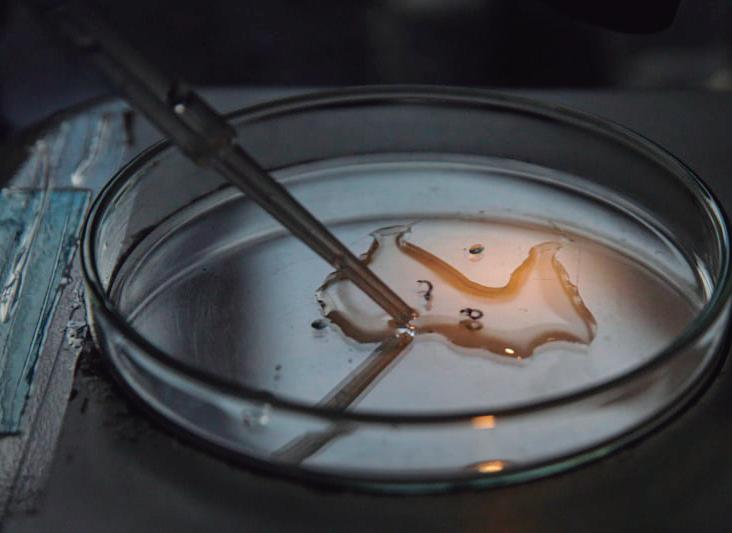

Segunda-feira, 22 de abril de 2024 | Ano 32 • Edição 10419
PROCON Saiba como comprar automóveis de forma segura
CONCURSO PÚBLICO BM abre inscrições para agente de apoio à educação
GERAL | Página 2
Homem é assaltado, chama a PM e acaba preso por tráfico
POLÍCIA | Página 4
Políticos da região comparecem a ato pró-Bolsonaro, em Copacabana
POLÍTICA | Página 3
Proposta vem sendo estudada desde 2023 e foi reforçada pelo deputado estadual Munir Neto ao secretário estadual de Segurança Pública
Em outubro de 2023, durante o Fórum de Segurança do Médio Paraíba, em Resende, o então secretário de Polícia Civil, José Renato Torres, anunciou a im-
de Segurança Publica, Victor dos Santos, o deputado estadual Munir Neto solicitou a construção de um Batalhão de Ações com Cães da Polícia Militar e reforçou o pedi-
do de uma Delegacia de Homicídios que beneficie toda a região.

ESPORTES | Página 6
Clube dos Funcionários doa cestas a vítimas de violência doméstica A Secretaria Municipal de Políticas para Mulheres e Direitos Humanos (SMDH) de Volta Redonda recebeu 20 cestas básicas doadas pela Direção do Clube dos Funcionários. A doação é o resultado da ação social que arrecadou recursos para comprar os itens que vão beneficiar mulheres em situação de violência doméstica e familiar.
CIDADES | Página 5
Alunos de VR lançam protótipo de equipamento para deficientes visuais




conquistou neste domigo (21) o 1º lugar na categoria Junior da 4ª etapa da Volta a Portugal. “Foram 120 km, deu aproximadamente quase 40 km de média. Fiz primeiro lugar na junior. Estou feliz com o meu resultado”, comemorou, aproveitando para agradecer ao apoio dos pais e de sua equipe. “Estou partindo para a próxima semana, uma semana de treino firme. E na outra semana, vou participar da Volta às Astúrias, na Espanha. Quatro etapas onde vão estar as melhores equipes da Europa, e vou ter a oportunidade de competir”, acrescentou. Guilherme Katraquinha começou com o pé direito sua segunda temporada na Europa. Na última semana, ele participou da Volta a Lollé, onde se destacou, em uma das etapas, como melhor escalador.
Ordem Pública recolhe carros abandonados em Volta Redonda
Mais de 20 veículos em estado de abandono foram retirados das vias públicas de Volta Redonda neste primeiro trimestre de 2024, numa ação da Secretaria Municipal de Ordem Pública (Semop).
Somente em 2023, de acordo com a pasta, 115 veículos foram removidos das ruas em estado de abandono. Neste ano, o número é de 22.
VOLTA REDONDA
Anúncio da Viagem da Melhor Idade terá show de ‘The Fevers’ no Comercial
A Prefeitura de Volta Redonda preparou um evento especial para anunciar oficialmente o destino da Viagem da Melhor Idade 2024. Este ano, a atração principal será o grupo ‘The Fevers’, banda de rock e pop que fez muito sucesso nas décadas de 60 e 70.
Durante o show, que acontece no Clube Comercial, na Colina,os participantes dos projetos para a
Melhor Idade das secretarias de Esporte e Lazer (Smel) e de Assistência Social (Smas) terão a confirmação de que o destino da viagem será Campos do Jordão, município paulista, na Serra da Mantiqueira. O evento está marcado para as 14h30 da próxima sexta-feira (26).

CIDADES | Página 5

R$ 2,00
plantação de duas delegacias especializadas em homicídios no Sul Fluminense. Uma delas ficaria em Volta Redonda. Esta semana, em reunião com o secretário estadual
POLÍTICA | Página 3
GERAL | Página 2
POLÍCIA | Página 4
VOLTA REDONDA
O ciclista de Barra Mansa, Guilherme Lino ‘Katraquinha’,
Samara Miranda/Remo
‘The Fevers’, banda de rock e pop, fez muito sucesso nas décadas de 60 e 70
“Vitória importante, mas muito no sufoco”, avaliou o técnico Rogério Corrêa
Bengala Inteligente se propõe a auxiliar pessoas com deficiência através de sinais sonoros e vibração
CIDADES | Página 5
Secom/PMVR
Reprodução

Procon-VR orienta consumidores sobre compra segura de automóveis
A Coordenadoria Municipal de Proteção e Defesa do Consumidor de Volta Redonda (Procon-VR) tem recebido diversas reclamações de consumidores em relação à compra de carro. Por isso, preparou uma série de orientações e dicas para que o consumidor não tenha problema ao adquirir seu automóvel, garantindo uma compra segura. “Temos notado um aumento de reclamações sobre valores diferentes quando chega o carnê de financiamento, problemas de vícios (defeitos), de falta de docu-
mentação. A orientação principal é que não se deve comprar um carro sem a consulta de um mecânico”, frisou o coordenador do Procon-VR, João Silveira. Dentre as orientações, o Procon-VR ressalta que, ao realizar a compra de um veículo, a pessoa deve exigir o laudo cautelar de empresas autorizadas, pois esse documento traz o histórico do carro, incluindo informações como: se o veículo for proveniente de leilão, se sofreu colisão que compromete a estrutura, as condições da mecânica do automóvel. Outra orientação é quanto à documentação do automóvel. O
Procon-VR orienta que o consumidor deve procurar a Ciretran (Circunscrição Regional de Trânsito) – órgão do Detran – para consultar se veículo se encontra totalmente desembaraçado e livre para comercialização. Quanto ao financiamento, o consumidor deve se atentar em relação à taxa de juros; ler atentamente todas as cláusulas do contrato, verificando se não estão incluindo seguros do veículo, seguros prestamistas e outros itens. “Muitos vendedores usam essa artimanha de inserir o seguro para se livrar de correção de possíveis vícios (defeitos).
Com isso, transferem para o comprador o custo de reparos e consertos. Isso é ilegal. É venda casada”, ressaltou o coordenador do Procon-VR.
Também é importante, segundo a autarquia, exigir no ato da compra o CRV (Certificado de Registro do Veículo) em nome de quem está vendendo. Se for a concessionária, o documento deve estar no nome da empresa. O Procon em Volta Redonda fica na Rua Leopoldo Marçal, Nº 117, no bairro Aterrado. O atendimento é realizado das 9h às 16h. O telefone de contato é (24) 3339-9205.
Brasil atinge 1,6 mil mortes confirmadas por dengue
BM tem inscrições abertas para concurso público para agente de apoio à educação
Barra Mansa
A Prefeitura de Barra Mansa está com inscrições abertas para o concurso público que oferece 25 vagas para agente de apoio à educação. As candidaturas podem ser realizadas até o dia 29 de abril (segunda-feira), através do site www.nossorumo.org.br – onde também é possível acessar o edital com todas as informações. A taxa de inscrição é de R$ 69.
Para estar apto ao cargo, o candidato deve ter concluído o ensino médio (com certificado para comprovação) até o dia da convocação. A prova vai ser realizada no dia 19 de maio e o resultado final será divulgado no dia 26 do mesmo mês.
Um agente de apoio à educação atua nas atividades escolares nas quais se fizer necessário, em todos os níveis e modalidades de ensino, ajudando alunos que precisem de apoio em determinadas tarefas a serem realizadas.
PROCESSO SELETIVO DA ASSISTÊNCIA SOCIAL
A Secretaria de Assistência Social e Direitos Humanos prorrogou as inscrições para o processo seletivo da pasta, que, anteriormente, seria feito nos dias 18 e 19 de abril. Com o novo prazo, os candidatos poderão se inscrever nos dias 25 e 26 de abril (quinta e sexta-feira). São 50 vagas disponíveis para a formação de cadastro reserva, com contratação temporária.
País
O Brasil alcançou a marca dos 1.601 óbitos por dengue confirmados em 2024. Além disso, outras duas mil mortes seguem em investigação e podem ter sido causadas pela doença, totalizando 3,6 mil mortes confirmadas ou suspeitas até o momento. Os dados são do painel de casos do Ministério da Saúde atualizado nessa sexta-feira (19).
O número de mortes confirmadas é 35% superior a todo o ano de 2023, quando 1.179 brasileiros perderam a vida para doença. A diferença entre os casos ainda em investigação de 2023 e 2024 supera os 1.707%. Do ano passado, apenas 114 ocorrências seguem em investigação.
ESTADOS
Proporcionalmente, as unidades da federação com a situação mais grave da doença, índice calculado por casos prováveis a cada 100 mil habitantes (coeficiente de incidência),
Em relação aos casos prováveis da doença, os números chegam a 3,535 milhões em 2024 contra 1,649 milhão em 2023, aumento de 114%. Já o coeficiente de incidência de casos por 100 mil habitantes cresceu de 773 em 2023 para 1.741 casos prováveis para cada 100 mil brasileiros em 2024. As mulheres são as mais afetadas pela doença, representando 55% das ocorrências prováveis, contra 44% de pessoas do sexo masculino. A faixa etária mais afetada é dos 20 aos 29 anos, com 358 mil mulheres dessa faixa etária atingidas contra 299 mil homens. Apesar do aumento expressivo no número de casos e óbitos, a letalidade da doença em relação ao total de casos teve leve redução. De uma letalidade de 4,83% em casos graves em 2023 para 4,35% em 2024. Além disso, a letalidade dos casos prováveis passou de 0,07% para 0,05% no mesmo período.

Mulheres são as mais afetadas pela doença, representando 55% das ocorrências prováveis
são: Distrito Federal (7,9 mil x 100 mil); Minas Gerais (5,3 mil x 100 mil); Paraná (3,0 mil x 100 mil); Espírito Santo (2,9 mil x 100 mil); Goiás (2,5 mil x 100 mil); Santa Catarina (2,0 mil x 100 mil); São Paulo (1,8 mil x 100 mil); e Rio de Janeiro (1,3 mil x 100 mil).
Na parte embaixo da tabela, com os melhores índices de incidência, estão os estados de Roraima (36 casos x 100 mil); Ceará (96 casos x 100 mil); Maranhão (128 casos x 100 mil); Sergipe (137 casos x 100 mil) e Alagoas (152 casos x 100 mil). Com informações da Agência Brasil
Nova espécie de dinossauro é descoberta na Bahia

Cientistas da Universidade do Estado do Rio de Janeiro identificaram uma nova espécie de dinossauro que viveu no Recôncavo Baiano. O trabalho também revelou os primeiros ossos de dinossauros descobertos na América do Sul, segundo a instituição. O espécime foi batizado como Tietasaura derbyiana, em homenagem ao romance Tieta do Agreste, do escritor Jorge Amado, e ao geólogo e naturalista Orville A. Derby, fundador do Serviço Geológico e Mineralógico do Brasil e um dos pioneiros da paleontologia brasileira. “No caso da obra Tieta, ela sai da cidade dela, some um tempo e depois volta trazendo um furdunço pra cidade onde ela nasceu. E esses materiais, numa alusão à história, fizeram a mesma coisa. São levados do Brasil há muito Fóssil de Tietasaura está no Museu de História Natural de Londres, na Inglaterra tempo e agora retornam com essas novas informações científicas e essa nova espécie de ornitísquia para o país”, explica uma das pesquisadoras do estudo da Uerj, a paleontóloga Kamila Bandeira, sobre a escolha do nome. A Tietasaura é a primeira espécie no Brasil de um dinossauro do grupo dos ornitísquios, de alimentação herbívora, caracterizados pelo focinho em forma de bico e pela estrutura da pélvis semelhante à das aves. Além disso, se nota a tendência da região em abrigar esses animais. “A Tieta-
De acordo com a vice-prefeita e secretária de Educação, Fátima Lima, o cargo de agente de apoio à educação é de extrema importância para o desenvolvimento dos estudantes.
“Estamos com esse concurso aberto para aquelas pessoas que gostam de estar no dia a dia da educação. Exercer o cargo de agente de apoio à educação é um grande compromisso, visto que estará ajudando principalmente aqueles que necessitam de uma atenção especial”, destacou Fátima.
Os cargos disponíveis são: agente educador para acolhimento institucional em abrigo (cuidador social), pedreiro, eletricista predial ou residencial, cozinheiro, coveiro, roçador e ajudante de funerária. Poderão se inscrever aqueles que já atuaram em qualquer função pela Prefeitura de Barra Mansa e tiveram a validade expirada de seus contratos de trabalho, por prazo determinado. No entanto, no ato da contratação, o candidato deverá ter pelo menos 06 (seis) meses de desligamento do último contrato com a prefeitura.
As inscrições podem ser feitas de forma presencial nas unidades dos Centros de Referência de Assistência Social (CRAS), localizadas nos bairros: Ano Bom, Boa Vista 2, Morada Verde, São Pedro, Vila Coringa, Vista Alegre, Vila Natal (Paraíso de Baixo) ou na sede de SMASDH, no Centro. O resultado preliminar será divulgado no dia 29 de abril pelo link: http://www.barramansa.rj.gov.br/transparencia
Vacinação contra o HPV: o que muda com a aplicação da dose única
Estado do Rio
A Secretaria de Estado de Saúde (SES-RJ) está adotando a nova estratégia do Ministério da Saúde da vacinação em dose única contra o vírus HPV, causador do câncer de colo do útero e de pênis, entre outros tipos de doença. A iniciativa segue as recomendações mais recentes da Organização Mundial de Saúde (OMS) e da Organização Pan-Americana da Saúde (Opas).
metimento, entre elas pessoas com HIV, transplantados e outras condições específicas, além de vítimas de violência sexual, podem receber a vacina pelo SUS até os 45 anos.
QUAIS SÃO OS PRINCIPAIS SINTOMAS DE HPV?
saura foi descrita com outros materiais de dinossauros na mesma pesquisa. Esses materiais são os mais antigos coletados na América do Sul. Hoje em dia temos uma diversidade muito alta de espécies na Argentina, no Brasil também. Mas os primeiros dinossauros da região foram coletados na Bahia”, destaca a paleontóloga. A equipe de paleontólogos, coordenada pelas pesquisadoras Kamila Bandeira e Valéria Gallo, ambas do Instituto de Biologia Roberto Alcantara Gomes, da Uerj, analisou fósseis coletados entre 1859 e 1906 na Bacia do Recôncavo, no leste da Bahia. Esses materiais eram considerados perdidos, mas foram encontrados recentemente no Museu de História Natural de Londres. Ainda não há previsão de retorno desses fósseis para o Brasil. Com informações da Agência Brasil.
Estudantes participam de visita à Justiça Eleitoral de VR
Os alunos e professores do Pré-Vestibular Cidadão participaram de uma visita guiada à Justiça Eleitoral de Volta Redonda. A visita foi pela coordenação do Movimento Ética na Polícita (MEP) com o objetivo de mostrar a importância da participação dos jovens no processo eleitoral, antes, durante e depois das eleições.
Cerca de 40 alunos participaram da visita guiada País
“O Prof. Dr. Ary Jorge, servidor da Justiça Eleitoral, designado pela direção da orgão, acolheu com outros três colegas os estudantes e apresentou as instalações e toda dinâmica operacional da Justiça Eleitoral. Apresentou

ainda de forma brilhante o ‘Projeto Eleitor do Futuro em Volta Redonda’, inserido na Escola Judiciária Eleitoral do TRE/RJ. Ary, na palestra mostrou a toda dinâmica do processo eleitoral e a confiabilidade das urnas eletrônicas, inclusive a nova urna eletrônica a ser utilizada nas eleições de outubro foi apresentada”, disse Pedro Paulo Vidal, bacharel em Direito, conselheiro e ex-estudante do MEP.
Maria Antonella, estudante do Pré-Vestibular Cidadão, elogiou as explicações do Prof. Ary Jorge. “Estamos gratos, foi muito bom. Aprendizados como esse deveria ser levado não só para os mais

jovens, mas para toda população, ainda mais no momento que o país vive. É muito importante a conscientização de como funciona a eleição, a história, a cre-
dibilidade do processo eleitoral e importância para a democracia. Oportunidade importantíssima”, afirmou a estudante, que pretende cursar Relações Internacionais.

De acordo com estudos, a vacinação pode reduzir em até 87% as taxas de câncer de colo do útero. O público-alvo da vacinação são meninos e meninas de 09 a 14 anos.
Diante da mudança na aplicação da vacina de duas doses para dose única, técnicos da Subsecretaria de Vigilância e Atenção Primária à Saúde (Subvaps) tiram as dúvidas mais frequentes sobre o tema.
POR QUE HOUVE A MUDANÇA DA VACINAÇÃO DO HPV PARA DOSE ÚNICA?
De acordo com o Ministério da Saúde, diversos estudos realizados mostram evidências robustas de que uma dose da vacina HPV, pode fornecer proteção igual a duas ou três doses (a depender da idade), em áreas com altas coberturas vacinais.
Segundo a OMS, a adoção da dose única, para a faixa etária de 9 a 20 anos de idade traria as seguintes vantagens: uma maior adesão à vacinação, aumento da cobertura vacinal e oportunidade para a inclusão de outros públicos prioritários, melhor logística e facilitação da introdução da vacina HPV em programas de imunizações nos países de média e baixa renda, e aceleração da eliminação do câncer de colo do útero, não só no Brasil, mas em nível mundial.
CRIANÇAS E ADOLESCENTES
QUE RECEBERAM A PRIMEIRA
DOSE PRECISAM SE VACINAR NOVAMENTE?
A orientação é que a vacinação seja em dose única para todas as pessoas dentro dessa faixa etária, quem já tomou pelo menos a primeira dose, já está imunizado contra o HPV.
ADULTOS TAMBÉM PODEM SE VACINAR CONTRA O HPV?
Adultos com imunocompro-
Os principais sintomas de infecção pelo HPV são o aparecimento de verrugas na região genital (pênis ou vagina) e no ânus, conhecidas popularmente como “crista de galo”, “figueira” ou “cavalo de crista”. Podem ser únicas ou múltiplas, de tamanhos achatadas ou elevadas e sólidas. Em geral são assintomáticas, mas podem causar coceira no local. Essas geralmente não são causadoras de cânceres. Além disso, existem lesões que são subclínicas (não visíveis ao olho nu) que podem também ser encontradas na região genital e ser desenvolvidas por tipos de HPV de baixo e alto risco para desenvolver câncer. É importante alertar que para um diagnóstico preciso é necessário a realização de exames clínicos e laboratoriais.
E COMO É O TRATAMENTO PARA QUEM ADQUIRIU HPV?
O tratamento contra o vírus do HPV é químico, cirúrgico ou com estimuladores da imunidade. Pode ser domiciliar, a partir da auto aplicação de medicamentos específicos ou ambulatoriais. O procedimento consiste na destruição das lesões. Independente de realizar o tratamento, as lesões podem desaparecer, permanecer inalteradas ou aumentar em número e/ou volume. As pessoas infectadas e suas parcerias devem retornar ao atendimento médico, caso identifique novas lesões.
PREVENÇÃO
O uso de preservativo (camisinha) nas relações sexuais é outra importante forma de prevenção do HPV. Contudo, o seu uso, apesar de prevenir a maioria das IST, não impede totalmente a infecção pelo HPV, pois muitas vezes as lesões estão presentes em áreas não protegidas pela camisinha (vulva, região pubiana, períneo ou bolsa escrotal). A camisinha feminina, que cobre também a vulva, é mais eficaz para evitar a infecção, se utilizada desde o início da relação sexual.

2 Segunda-feira, 22 de abril de 2024 Editor Responsável: Vinicius Ramos Pereira Diretora Geral: Renata Pançardes Editor Internacional: Silas Avila Jr. Redação: redacao@diariodovale.com.br Anúncios: anuncio@diariodovale.com.br Comercial: comercial@diariodovale.com.br © Copyright 2023 Empresa Jornalística Diário do Vale Ltda. Todos os direitos reservados. É proibida a reprodução total ou parcial do conteúdo do Diário do Vale em quaisquer meios de comunicação, eletrônicos ou impressos, assim como em sites comerciais, sem a autorização por escrito do detentor dos direitos autorais. A proibição se aplica tanto ao conteúdo da edição impressa, quanto da edição online do Diário do Vale. É permitido, porém, o uso de links direcionados ao site do Diário do Vale ou a páginas do seu conteúdo. Diretor-Presidente Luciano Rodrigo Pançardes MTB 32.873/RJ Fundador: Aurélio José F. de Paiva www.diariodovale.com.br Site ativo desde 1996 Sede: Rua Simão da Cunha Gago, n° 145 - Ed. Maximum Sls. 713 / 714 - Aterrado - Volta Redonda - CEP 27213-170 Telefone geral: (24) 99234-8846 Whatsapp do jornalismo: (24) 99926-5051 Auditado Segunda a sexta-feira, das 9 às 17h (24) 99234-8846 anuncio@diariodovale.com.br Atendimento ao cliente Av. Rio Branco, 173 / 602 e 603 Centro - Rio de Janeiro Tel: (21) 2262-7469 / (21) 97594-8659 Representante Comercial Exclusivo J.C. Representações e Publicidades Ltda GERAL
Redonda
Volta
Volta Redonda
Divulgação
Divulgação/Thales Nascimento
Marcelo Camargo / Agência Brasil

Batalhão de Cães e Delegacia de Homicídios podem ser implantados em VR
Sugestão foi dada ao secretário estadual de Segurança pelo deputado estadual Munir Neto; medida pode reforçar segurança em todo o Sul Fluminense
Sul Fluminense
Em reunião com o secretário estadual de Segurança Publica, Victor dos Santos, o deputado estadual Munir Neto solicitou a construção de um Batalhão de Ações com Cães da Polícia Militar e de uma Delegacia de Homicídios. O anúncio foi feito neste sábado (20). De acordo com Munir, as unidades seriam construídas em Volta Redonda, com o aval do prefeito Antônio Francisco Neto , para atender o Médio Paraíba.
“O Instituto de Segurança Pública (ISP) mostrou nas últimas pesquisas que em nossa região tem acontecido mais mortes do que roubos e furtos. Por isso, a importância de construirmos uma Delegacia de Homicídios. O prefeito Neto concorda e apoia em tudo. Essa seria uma excelente estratégia para melhorar a Segurança da nossa reunião”, destacou Munir, frisando também a importância do trabalho com os cães.
“O Neto ficou de doar o terreno em local estratégico para a construção das edificações. Queremos uma Cia Avançada com instalações administrativas, alojamento, rancho, clínica veterinária,

BAIRRO PRESENTE NA
REGIÃO LESTE
Munir também levou ao co-
Câmara Municipal promulga lei que cria
Procuradoria
da Mulher em Barra do Piraí
Objetivo do órgão é contribuir com a implementação de políticas públicas para mulheres
Barra do Piraí
A Câmara Municipal de Barra do Piraí promulgou o Projeto de Resolução de autoria da vereadora Kátia Miki (Solidariedade) que cria a Procuradoria da Mulher no Legislativo Municipal.
O órgão, que vai funcionar na sede do Poder Legislativo, tem como principal objetivo a contribuição na implementação de políticas públicas para as mulheres e na defesa dos interesses desse público que representa 53% dos cidadãos barrenses, de acordo com o último Censo do IBGE.
De acordo com a vereadora, a Procuradoria da Mulher vai também receber, examinar e encaminhar aos órgãos competentes, denúncias de violência e discriminação.
“Recentemente o nosso município ganhou uma subsecretaria da Mulher que funciona dentro da estrutura da secretaria municipal de Saúde. Foi um avanço muito pequeno. Precisamos que o governo municipal
tenha um olhar de equidade, propondo políticas públicas e construindo equipamentos de acolhimento, abrigo e proteção”, disse Kátia.
A ideia da criação da Procuradoria da Mulher surgiu para suprir a ausência de órgãos que pensassem no direto da mulher como um todo, não apenas na área da Saúde. A Resolução, de acordo com a parlamentar, vai garantir fiscalização e acompanhamento de ações e programas, debates com a comunidade, pesquisas e estudos sobre violência e discriminação e acolhida e escuta.
PROCURADORIA DA MULHER DA CÂMARA FEDERAL
Kátia aproveitou a ida a Brasília na última semana, para conhecer a Procuradoria da Mulher da Câmara Federal e se encontrou com a Procuradora, a deputada federal Soraya Santos (PL/RJ). “Foi uma excelente oportunidade para conhecer o trabalho que vem sendo realizado com



Rio Políticos da região Sul Fluminense estiveram presentes ao ato de apoio ao ex-presidente Jair Bolsonaro, realizado neste domingo (21), na orla da praia de Copacabana, na Zona Sul do Rio. O vereador e pré-candidato a prefeito de Barra Mansa, Luiz Antônio Furlani, foi um dos presentes. Em suas redes sociais, ele compartilhou registros do evento e fotos ao lado de personalidades da direita. O empresário Bruno Marini, também de Barra Mansa e também pré-candidato à prefeitura, encontrou-se com um dos filhos do ex-presidente, o

Fundação Francisco Dornelles é lançada durante reunião do PP
Homenagem contou com a participação do governador Claudio Castro, do secretário de Estado de Turismo Gustavo Tutuca e do presidente da Câmara dos Deputados, Arthur Lira

Rio
Foi realizada, na manhã deste sábado (20), no Rio de Janeiro, a cerimônia de criação da Fundação Francisco Dornelles, que anteriormente chamava-se Fundação Milton Campos.
O evento contou com a participação do governador Cláudio Castro, do presidente da Câmara dos Deputados, Arthur
Lira, do secretário de Estado de Turismo, Gustavo Tutuca, do deputado federal Doutor Luizinho, líder do Partido Progressistas na Câmara dos Deputados e de vários políticos. Francisco Dornelles, falecido em 2023, aos 88 anos, era presidente de honra do Progressistas e atuou como ministro, deputado, senador, vice-governador e governador do Rio de Janeiro.
Jari propõe regulamentação para gestão de resíduos orgânicos compostados
Sul Fluminense
O deputado estadual Jari Oliveira (PSB) elaborou um Projeto de Lei que estabelece diretrizes para a gestão estadual e regional de resíduos sólidos orgânicos que possam ser tratados por meio de compostagem. De acordo com ele, a ação - que deve ser gerida pelos municípios fluminenses e pelos Consórcios Públicos Interfederativos - está em consonância com o Plano Estadual de Resíduos Sólidos do Rio de Janeiro. “Essa é mais uma ação voltada para a preservação do meio ambiente, uma das prioridades do meu mandato na Alerj. Já existem diversas ações voltadas para reciclagem do material inorgânico, enquanto o orgânico, em sua maioria, é despejado em aterros sanitários ou até mesmo em lixões. Com esta proposta, pretendo dar uso adequado, transformando o resíduo orgânico num país com elevada produção agrícola e que, para tanto, importa fertilizantes”, afirmou Jari.
Pela proposta , o sistema de coleta de resíduos sólidos orgânicos será instalado independentemente do sistema de coleta seletiva dos resíduos sólidos recicláveis e da prestação da coleta regular dos resíduos sólidos. E os municípios fluminenses e os Consórcios Públicos Interfederativos, em articulação com o Estado, deverão incentivar aos moradores das áreas urbanas - quando couber - e rurais a fazer a segregação na origem desses resíduos e fazer uso de composteiras domésticas.
O projeto ressalta que prestadores públicos e privados, nos termos autorizados pelos Municípios fluminenses e pelos Consórcios Públicos Interfederativos, deverão recolher os resíduos sólidos orgânicos e encaminhá-los para tratamento por meio da compostagem.
O Estado poderá conferir suporte técnico e financeiro para os Consórcios Públicos Interfederativos e os Municípios fluminenses para a instalação de unidades de compostagem para tratamento dos resíduos sólidos orgânicos, utilizando recursos
do Fundo Estadual de Conservação Ambiental e Desenvolvimento Urbano (FECAM).
CIRCULAÇÃO DE RECURSOS
O projeto de Jari prevê ainda que os recursos advindos da comercialização do composto produzido por iniciativa dos Consórcios Públicos Interfederativos e dos municípios fluminenses deverão ser revertidos para os mesmos, para que estes recursos possam ser aplicados na manutenção e ampliação do sistema de coleta e tratamento de resíduos sólidos orgânicos.
O adubo composto produzido pelas unidades de compostagem poderá ser destinado, gratuitamente, para projetos de agricultura familiar. O Estado também deverá priorizar a aquisição de alimentos orgânicos produzidos por projetos de agricultura familiar, cujo processo agrícola tenha empregado composto orgânico.
IDEIA
A ideia para o projeto chegou ao deputado Jari através do professor Roberto Guião de Souza Lima Junior, que atua no UniFOA (Centro Universitário de Volta Redonda), que desenvolve projetos de educação ambiental pela UFF (Universidade Federal Fluminense) e trabalha diretamente com compostagem de resíduos sólidos orgânicos. Um dos projetos ocorre em parceria com o Clube dos Funcionários, em Volta Redonda. “O Brasil, de maneira geral, segue a linha da Política Nacional de Resíduos Sólidos, que sugere a compostagem e outras formas de tratamento, mas não obriga que seja feito. Então, estamos há 14 anos da implantação dessa política e não avançamos no setor para tratamento de orgânicos, que é o principal causador de efeito estufa nos aterros sanitários. Além disso, perdemos o potencial de nutrientes que esse resíduo tem para ser incorporado na agricultura, evitando utilização de componentes químicos, fazendo uma manejo agrícola mais adequado ao meio ambiente”, falou o professor.

3 Segunda-feira, 22 de abril de 2024 POLÍTICA
deputado federal Eduardo Bolsonaro. Representando Volta Redonda esteve o advogado e vereador Rodrigo Furtado, que aproveitou a oportunidade para fazer um vídeo ao lado do personagem ‘ Milei de Floripa’, além de ter se encontrado com Valdemar Costa Neto, presidente do Partido Liberal (PL). O ato público, convocado por Jair Bolsonaro pelas redes sociais, é o segundo deste ano. O primeiro foi realizado no final de fevereiro, em São Paulo. No Rio, Bolsonaro subiu ao trio elétrico para discursar a seus apoioadores por volta das 10h30, acompanhado pelo governador do Estado do Rio, Cláudio Castro. Também acompanharam
seu
e o pastor Silas
dentre outros. Políticos do Sul Fluminense participam de ato pró-Bolsonaro no Rio Fotos: Reprodução Redes Sociais
o ex-presidente
filho, o senador Flávio Bolsonaro,
Malafaia,
Bruno Marini encontrou-se com o deputado federal Eduardo Bolsonaro Furlani tirou fotos com Eduardo Pazuello, deputado federal e ex-ministro da Saúde Rodrigo Furtado fez stories para o Instagram com o pastor Silas Malafaia
Divulgação
Sugestão foi feita por Munir em reunião com o secretário estadual de Segurança, Victor dos Santos
canil e campo de treinamento e adestramento dos cães”, disse.
nhecimento do secretário a indicação de sua autoria que solicita a implantação do Bairro Presente na Região Leste de Barra Mansa. “Os projetos Segurança Presente e Bairro Presente ajudaram muito na queda da criminalidade de Volta Redonda e diversos municípios do estado. A Região Leste, em especial, o bairro Nove de Abril merece essa atenção. Junto com o nosso governador Cláudio Castro estamos fortalecendo o Sul Fluminense”, concluiu.
excelência pela deputada Soraya Santos na Procuradoria da Mulher na Câmara Federal. Já absorvi várias ideias para levarmos para Barra do Piraí. Agora sim as mulheres serão verdadeiramente representadas”, concluiu a parlamentar.
Divulgação
Kátia Miki foi a Brasília encontrar a deputada federal Soraya Santos
Reprodução
Evento contou com a participação de diversos políticos, incluindo o prefeito do Rio, Eduardo Paes, e o deputado federal Julio Lopes

Vítima de assalto em VR
é presa por tráfico de drogas
Assaltado na Praça Japão na noite de sexta-feira (19), ele cumprirá seis anos de prisão
Um homem de 28 anos foi preso na noite desta sexta-feira (19) ao ser levado à 93ª Delegacia de Polícia para registrar um assalto do qual foi vítima. De acordo com a ocorrência, uma guarnição da Polícia Militar foi acionada pelo Centro Integrado de Operações de Segurança Pública (Ciosp) para verificar um caso de assalto a transeunte na Vila Santa Cecília. No local, a vítima contou aos policiais que marcou encontro com uma mulher - da qual não soube dizer o nome -, indo com ela até a Praça Japão. No local, outro homem apareceu e o assaltou, levando todos os seus pertences. A vítima
não soube informar as características do assaltante e disse acreditar que foi enganado pela mulher, que teria atraído-o para a Praça Japão justamente para que fosse assaltado. A guarnição da PM fez patrulhamento na área para localizar os envolvidos, sem sucesso. Diante disso, a vítima foi levada à 93ª DP para
o registro da ocorrência. Na distrital, os policiais descobriram que contra a vítima havia em aberto um mandado de prisão condenatória por tráfico de drogas. O mandado foi cumprido, e o homem permanece preso e à disposição da Justiça. Ele cumprirá pena de seis anos em regime fechado.
Ordem Pública recolhe veículos abandonados em Volta Redonda
Mais de 20 automóveis foram retirados das ruas no primeiro trimestre deste ano
Mais de 20 veículos em estado de abandono foram retirados das vias públicas de Volta Redonda neste primeiro trimestre de 2024, numa ação da Secretaria Municipal de Ordem Pública (Semop). A ação conta ainda com a atuação da Guarda Municipal de Volta Redonda (GMVR).
Somente em 2023, de acordo com a pasta, 115 veículos foram removidos das ruas em estado de abandono. Neste ano, o número é de 22. A remoção visa a segurança primária e é prevista no Decreto 15.601/19, também levando em consideração riscos à saúde pública. A atuação da Guarda Municipal é respaldada também pelo Código Civil Brasileiro e pelo CTB (Código de Trânsito Brasileiro).
O secretário municipal de Ordem Pública, tenente-coronel Luiz Henrique Monteiro Barbosa, destacou que a ação tem como foco principal a segurança primária, que trata do ambiente, gerando uma maior sensação de segurança.
“O nosso objetivo é atuar na redução de condições propícias ao delito. Um carro abandonado pode servir para atos ilícitos, bem como um problema de saúde pública, se tornando criadouro do mosquito da dengue, entre outros problemas”, apontou.
O secretário lembrou que

a ação da Semop e da GMVR oportuniza aos proprietários desses veículos em estado de abandono que os levem para um lugar seguro e coberto onde possam deixá-los, inclusive cedendo o guincho da GMVR, caso não haja meios de locomover o veículo. “Acreditamos que a me-
lhor solução é a harmônica. Por isso, antes da remoção realizamos a notificação do proprietário e ele tem um prazo para a retirada desse veículo. Caso isso não seja respeitado, o veículo é removido e encaminhado ao depósito público municipal”, explicou o secretário Luiz Henrique. O titular da secretaria de Ordem Pública ainda ressaltou a importância da população nesse trabalho. “A população pode e deve nos ajudar sempre com denúncias, que podem ser feitas pelos telefones 156, da Central de Atendimento Único (CAU), ou da Guarda Municipal, o 153”, concluiu.
Homem é preso com crack e cocaína em Porto Real
Suspeito possui passagens por tráfico de drogas, violência doméstica e ameaça
Porto Real
Um homem de 22 anos foi preso, na manhã deste domingo (21), com drogas na Rua Oito, no bairro Jardim das Acácias, em Porto Real. Ele tem passagens pelos crimes de tráfico de drogas, violência doméstica e ameaça.
CPRv prende mulher com 2,5 mil pinos de cocaína

Piraí
Agentes da Polícia Rodoviária Estadual (CPRv), prenderam na madrugada de sábado (20) uma mulher que transportava cerca de 2.500 pinos de cocaína. De acordo com a Polícia, as
drogas seriam comercializadas no município de Barra do Piraí. A droga pertencia à facção do CV e tinha como origem o Complexo do Alemão, no Rio. O veículo e a motorista foram conduzidos para a delegaciade Polícia Civil em Piraí.
Família busca paradeiro de jovem desaparecido em VR

Volta Redonda
Um jovem de 27 anos, residente do bairro Santa Cruz, no Ingá II, em Volta Redonda, está desaparecido desde a última quarta-feira (17). Augusto Kalil Mendes Júnior, recém-contratado pela CBSI, empresa terceirizada da CSN, não é visto desde então.
O desaparecimento foi reportado na tarde deste domingo (21) pela mãe de Augusto. Ele recentemente ingressou na CBSI, começando suas atividades na terça-feira (16). No entanto, já no dia seguinte, por volta das 17h, Augusto não compareceu ao trabalho.
Qualquer informação que possa ajudar a encontrar seu paradeiro pode ser comunicada através dos números (24) 993066708 ou (24) 99312-5454.
Agentes do 37º Batalhão de Polícia Militar foram até o local após receberem uma denúncia sobre um ponto de tráfico de drogas em funcionamento. Os policiais estabeleceram um perímetro de vigilância e conseguiram identificar o suspeito mencionado na denúncia. Durante a abordagem, foram apreendidas 699 pedras de crack, um tablete de crack, quatro pinos de cocaína, uma balança de precisão, material utilizado para embalar drogas, dois celulares e R$ 272,00. Todo o material ilícito foi apreendido e levado, juntamente com o suspeito, à 100ª DP, onde a ocorrência foi registrada.
Homem foi detido com 699 pedras de crack


Homem é preso com frascos de lança-perfume em Resende
Suspeito foi detido no bairro Vicentina
Resende
Um homem de 26 anos foi preso, na tarde deste sábado (20), na Rua Prefeito Clodomiro Maia, próximo à quadra do bairro Vicentina, em Resende.
Agentes do 37º Batalhão de Polícia Militar abordaram o suspeito durante patrulhamento de rotina no local. O homem teria tentado se esconder atrás
de um veículo ao notar a aproximação da viatura. Durante a revista, os policiais encontraram com o homem uma sacola contendo 24 frascos de lança-perfume. Além da droga, foram apreendidos um celular e R$ 9,00.
O suspeito foi encaminhado para a 89ª Delegacia de Polícia (DP), onde a ocorrência foi registrada.
Suspeito de tráfico é preso com drogas no Açude
Volta Redonda
Um homem de 24 anos foi preso com crack e maconha na manhã deste sábado (20), no bairro Açude, em Volta Redonda. Após receberem uma denúncia, agentes do 28º Batalhão de Polícia Militar (BPM) foram até o endereço e conseguiram localizar e deter o suspeito com o material entorpecente. Foram apreendidos durante a ação: 291 pedras de crack, seis tiras de maconha, uma balança e várias etiquetas. O suspeito e o material apreendido foram levados à 93ª DP, onde a ocorrência foi registrada.

4 Segunda-feira, 22 de abril de 2024 POLÍCIA
Volta Redonda
Volta Redonda
PIRAÍ
Reprodução
O veículo, as drogas e a condutora foram levados para a delegacia de Piraí
Reprodução Reprodução Augusto não é visto desde terça-feira (16)
Reprodução Homem foi detido com 24 frascos de lança-perfume e R$ 9
Ação da Semop e da GMVR oportuniza aos proprietários de veículos em estado de abandono que os levem para um lugar seguro e coberto
Divulgação/Semop
VR: 'The Fevers' é atração durante anúncio oficial da Viagem da Melhor Idade 2024
Este ano, idosos participantes vão viajar para Campos do Jordão (SP); show acontece na próxima sexta-feira (26), no Clube Comercial
Volta Redonda
A Prefeitura de Volta Redonda preparou um evento especial para anunciar oficialmente o destino da Viagem da Melhor Idade 2024. Este ano, a atração principal será o grupo 'The Fevers', banda de rock e pop que fez muito sucesso nas décadas de 60 e 70.
Durante o show, que acontece no Clube Comercial, na Colina,os participantes dos projetos para a Melhor Idade das secretarias de Esporte e Lazer (Smel) e de Assistência Social (Smas) terão a confirmação de que o destino da viagem será Campos do Jordão, município paulista, na Serra da Mantiqueira. O evento está marcado para as 14h30 da próxima sexta-feira (26).
O programa 'Viva a Melhor Idade' vai beneficiar cerca de dez mil idosos em 2024. Eles serão divididos em 44 grupos e a primeira turma viaja no dia 30 de abril (terça-feira). As viagens seguem nos meses de maio, agosto, setembro, outubro, novembro, encerrando no dia 16 de dezembro.
Durante o evento que vai confirmar o destino da viagem, serão entregues os folders com todas
as informações sobre o passeio. A programação está dividida em dois dias e inclui passeio por Capivari, centro turístico de Campos do Jordão, onde estão várias lojas, cafeterias e chocolaterias, e também pelo Parque Capivari, um espaço amplo e moderno, recentemente revitalizado, que conta com um carrossel bem romântico, uma roda-gigante e lago.
Além de conhecer Campos do Jordão – o mais alto município brasileiro, considerado estância climática e chamado de 'Suíça Brasileira', com sua arquitetura de inspiração alemã –, a Melhor Idade contará com todas as comodidades do Hotel Estoril, onde ficará hospedada. Os idosos serão recebidos com almoço e no primeiro dia ainda tem bingo, seguido de chá da tarde, jantar e baile com música ao vivo. No segundo dia do passeio estão incluídos café da manhã e almoço.
O prefeito Antônio Francisco Neto, que idealizou o programa 'Viva a Melhor Idade', afirmou que a viagem é a cereja do bolo de todas as ações que a prefeitura promove para dar uma qualidade de vida melhor à Terceira Idade.
“São pessoas que sempre acre-

ditaram e ajudaram a construir a história da cidade. Retomamos os passeios, com estadia em hotel de luxo, em 2022, após a pandemia e já beneficiamos mais de 15 mil
idosos somente nesses dois anos. Eles já foram a Teresópolis (RJ) e Caxambu (MG), desta vez, o destino é a bela cidade paulista de Campos do Jordão”, lembrou Neto.
Alunos do Colégio João XXIII desenvolvem protótipo de 'bengala inteligente'
Uma bengala inteligente: é esse o projeto desenvolvido por alunos do último ano do Ensino Fundamental do Colégio João XXIII, unidade da Fevre (Fundação Educacional de Volta Redonda), no Retiro. O anúncio foi feito pela prefeitura neste sábado (20). Os estudantes de Robótica da unidade de ensino participam da iniciativa, uma parceria entre a Fevre e a Secretaria Municipal da Pessoa com Deficiência (SMPD), para criar bengalas inteligentes para os deficientes visuais assistidos pela SMPD.
Dois protótipos já saíram do papel, foram apresentados e testados por uma aluna com deficiência visual. Taís avaliou as bengalas, testou os protótipos e apontou melhorias que podem ser feitas pelos alunos para facilitar a utilização.
OBJETIVO
A Bengala Inteligente se propõe a auxiliar pessoas com deficiência através de sinais sonoros, quando se aproxima de um obstáculo. E ainda conta com o recurso de vi-

brar quando está próxima demais de algo que esteja atrapalhando o percurso. Assim que não houver mais obstrução no caminho, a vibração para. A bengala é fácil de transportar, tem botões de toque e vai utilizar bateria recarregável. O presidente da Fevre, Caio Teixeira, avaliou a iniciativa como fundamental e destacou o papel dos estudantes neste projeto. “É uma enorme satisfação a gente poder apoiar um projeto desse,
que ajuda as pessoas com deficiência e, principalmente, ver que isso está sendo feito por alunos. Estamos ajudando e educando no mesmo projeto”, afirmou Caio.
A secretária da Pessoa com Deficiência, Eliete Vasques, também elogiou o projeto. “É com grande entusiasmo e orgulho que comento sobre o extraordinário projeto desenvolvido por alunos da Fevre, que se dedicaram à criação de uma bengala automatizada para deficientes
visuais. Ao utilizar a robótica para melhorar a mobilidade e a independência de pessoas com deficiência, este projeto reforça a ideia de que a tecnologia pode e deve ser uma aliada na superação de barreiras físicas e sociais”, frisou Eliete. Professor de Robótica e mentor dos alunos na ideia da Bengala Inteligente, Frederico Pitasse, destacou a questão social da iniciativa. “Aqui, a gente trabalha muito com competição, mas sempre nos preocupamos também com o social. E a partir das ideias dos alunos, juntamente com a secretaria, nós desenvolvemos a bengala inteligente, que é o nosso protótipo, onde a gente vem trabalhando para ajudar de uma forma geral a população”, ressaltou Frederico. Aluno do projeto de robótica e membro da equipe que está desenvolvendo a Bengala Inteligente, Luiz Filipe Pires, contou como é participar da iniciativa. “É bem mais gratificante do que participar de uma competição, em um campeonato você ganha no máximo uma medalha, neste projeto nós mudamos a vida de muitas pessoas”, salientou.
Vítimas de violência doméstica recebem cestas básicas em Volta Redonda
Volta Redonda
A Secretaria Municipal de Políticas para Mulheres e Direitos Humanos (SMDH) de Volta Redonda recebeu 20 cestas básicas doadas pela Direção do Clube dos Funcionários. A doação é o resultado da ação social que arrecadou recursos para comprar os itens que vão beneficiar mulheres em situação de violência doméstica e familiar.
O presidente do Clube dos Funcionários, Gustavo Tramontin, acompanhado da esposa, Michele Dias Tramontin, e o presidente do Conselho Deliberativo do Clube, Alyson Santana, estiveram na sede da SMDH, onde fizeram a entrega das cestas básicas à Secretaria, sendo recebidos pela secretária municipal Glória Amorim e assessoras.
Os recursos financeiros para a compra das cestas básicas vieram da atividade social com a venda de roupas doadas – novas e seminovas – realizada na PET (Praça de Esportes Tabajaras) do clube, na Vila Santa Cecília, com o projeto ‘Arara Solidária’. As peças de roupas foram doadas por empresas
e pessoas físicas, associados, não associados e vendidas durante o evento ‘Arara Solidária'.
CESTAS FORAM DIRECIONADAS AO CEAM
As cestas básicas foram direcionadas ao Ceam (Centro Especializado de Atendimento à Mulher), órgão ligado à SMDH que faz o atendimento com uma equipe multidisciplinar – advogadas, psicólogas e assistentes sociais –para mulheres em situação de violência doméstica e familiar.
A secretária Glória Amorim, acompanhada da coordenadora do Ceam, Vanilda Coutinho, e da advogada Patrícia Vieitas, que é assessora jurídica do centro especializado, agradeceu à direção do clube pela contribuição. “O evento foi muito bem organizado por vocês e fico muito satisfeita em receber a doação das cestas básicas, que vão ajudar famílias, mulheres que realmente precisam muito. Às vezes, a mulher tem que sair de casa sem levar quase nada, além de roupas e documentos, para proteger a própria integridade e dos filhos”.

Recursos para a compra das cestas básicas vieram do projeto 'Arara Solidária', realizada pelo Clube dos Funcionários
O presidente do clube, Gustavo Tramontin, deu uma boa notícia para a secretária e equipe: “Eu ainda tenho mais um ano de mandato e queremos fazer nesse tempo uma segunda edição do projeto ‘Arara Solidária’ para entregar mais cestas básicas. Ficamos felizes em contribuir com esta ação social”. Gustavo disse ainda que o clube atende mais de 20 instituições cadastradas para receber doações, e que fará um rodízio para aumentar as contribuições e continuar contribuindo com a
secretaria no atendimento às mulheres mais vulneráveis.
A esposa, Michele Tramontim, acrescentou: “A gente ouve falar em violência contra a mulher, mas não media a dimensão, a gravidade do fato. A realidade é muito dura e foi preciso trazer este entendimento para o coração das pessoas com esta ação social, na qual elas foram motivadas a participar. É uma honra para a gente, para o Clube dos Funcionários, uma vitória poder participar desse projeto em benefício das mulheres “, frisou.

Igreja Universal realiza Caminhada do Amor em Barra Mansa
Oitava edição da “The Love Walk” contou com palestras e atrações musicais Divulgação

Barra Mansa
A Igreja Universal realizou a 8ª edição da Caminhada do Amor (The Love Walk) na manhã deste sábado (20), no Parque Municipal de Saudade, em Barra Mansa. O evento contou com palestras, atrações musicais e teve como objetivo fortalecer a comunicação entre casais. Solteiros que participaram da Caminhada do Amor também experienciaram um momento dedicado a conhecer uns
aos outros. O pastor Divino Gomes, um dos organizadores e professores do evento, falou sobre as motivações e atividades da “The Love Walk”. “A Caminhada do Amor (The Love Walk) foi idealizada no intuito de resolver as falhas de comunicação entre os casais que sofrem pela falta de diálogo. O evento contou com atrações musicais e uma palestra prática e descontraída e tivemos o momento especial para os solteiros se conhecerem”, relatou o pastor Divino Gomes.
BM: Restaurante do Povo funcionará normalmente nesta segunda-feira (22)
Unidade estará fechada apenas na terçafeira (23), é feriado estadual de São Jorge

Unidade funcionará ainda na quarta, quinta e sexta-feira desta semana
Barra Mansa
O Restaurante do Povo
Irmã Ruth, em Barra Mansa, segue ofertando três refeições diárias a preços populares; café da manhã por R$ 0,50; almoço e jantar por R$ 1,00. Esta semana, o restaurante abrirá normalmente nesta segunda-feira (22) , véspera de feriado e fechará na terça-feira (23), devido ao feriado estadual de São Jorge - data de celebração do santo, um dos padroeiros do Estado. A unidade funcionará ainda na quarta, quinta e sexta-feira. O café da manhã será servido das 06h30 às 9h e contará com pão francês com margarina e café preto ou café com leite. O almoço será servido das 10h30 às 14h e o jantar das 18h às 20h.
CONFIRA O CARDÁPIO DE ALMOÇO E JANTAR
SEGUNDA-FEIRA (22/04)
• ALMOÇO: Arroz/feijão carioca, frango assado, purê de batata, salada mix de folhas e cenoura
• JANTAR: Arroz colorido/feijão carioca, linguiça calabresa, canjiquinha, salada mix de folhas e cenoura
• SOBREMESA: Doce tablete
• SUCO: Limão
QUARTA-FEIRA (24/04)
• ALMOÇO: Arroz colorido/ feijão carioca, frango assado, macarrão parafuso alho e óleo, salada de acelga e pepino
• JANTAR: Arroz/feijão preto, hambúrguer bovino, macarrão parafuso alho e óleo, salada de acelga e pepino
• SOBREMESA: Doce tablete
• SUCO: Morango
QUINTA-FEIRA (25/04)
• ALMOÇO: Arroz branco/feijão preto, suíno ao molho de abacaxi, ovos cozidos, quibebe de abóbora, salada de alface e beterraba
• JANTAR: Arroz com milho/ feijão carioca, frango grelhado, quibebe de abóbora, salada de alface e beterraba
• SOBREMESA: Gelatina de morango
• SUCO: Abacaxi
SEXTA-FEIRA (26/04)
• ALMOÇO: Arroz/feijão preto, farofa de alho, feijoada, ovos cozidos, salada de repolho e tomate
• JANTAR: Arroz/feijão preto, cubos bovinos com mandioca, farofa de alho, salada de repolho e tabule
• SOBREMESA: Laranja
• SUCO: Uva
5 Segunda-feira, 22 de abril de 2024 CIDADES
Volta Redonda
visa a resolver as falhas de comunicação entre casais que sofrem pela falta de diálogo
Iniciativa
Felipe Vieira/Arquivo PMBM
Divulgação Atração principal será o grupo 'The Fevers', banda de rock e pop que fez muito sucesso nas décadas de 60 e 70
Divulgação
Secom/PMVR
Projeto reforça a ideia de que a tecnologia pode ser uma aliada na superação de barreiras físicas e sociais